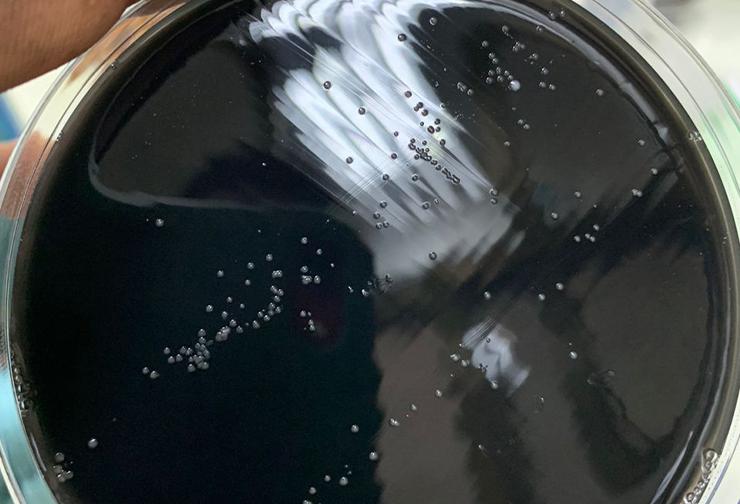
image

Caractérisation des Campylobacter dans une approche « One Health »

Caractérisation des Campylobacter dans une approche « One Health » à l’Unité de Génomique des Pathogènes One Health (UGenoPath-OH) /LaBESTA de l’Université Joseph KI-ZERBO
Du 16 au 20 mai 2023 a eu lieu à l’Unité de génomique des pathogènes One Health (UGenoPath-OH) /LaBESTA de l’Université Joseph KI-ZERBO une formation sur la caractérisation de Campylobacter selon l’approche « One Health ».
L’objectif de cet atelier est d’outiller les Mastérants, Doctorants aux techniques de culture et d’identification de souche de Campylobacter.
Plus spécifiquement il s’agit de :
• Réaliser une culture et identifier les souches de Campylobacter à partir d’échantillon d’intestin de poulet sur un milieu spécifique : la gélose Karmali ;
• Réaliser une culture et identifier les souches pour la recherche de Campylobacter à partir d’échantillon de selle sur la gélose Karmali ;
• Réaliser une culture et identifier les souches pour la recherche de Campylobacter à partir d’échantillon de l’environnement (effluent d’abattoir de volaille) sur la gélose Karmali.
Cette formation est initiée dans le cadre de l’implémentation de l’axe de recherche des activités sur leur thématique : Epidémiologie des Campylobacter et approche « One Health ».
A la fin de cette formation les étudiants ont été outillés sur la caractérisation des de Campylobacter selon l’approche « One Health ».
#UGenoPath-OH : Unité de Génomique des Pathogènes One Health
#LaBESTA : Laboratoire de Biologie moléculaire, d’épidémiologie et de surveillance des bactéries et virus transmissibles par l’Eau et les Aliments